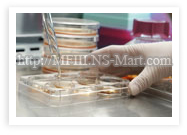
EUF臨床實驗

EUF 超能濾液LPPSIM
有效緩解糖尿病及其癥狀!!
EUF 生態超能濾液 LPPSIM
(肝臟胰腺胎盤胃腸粘膜)
◆ 適用於:1. 糖尿病(類型1及2) 2. 糖尿病前期癥狀(衰退性葡萄糖新陳代謝) 3. 高血壓 4. 50歲以上人群 5. 肥胖 6. 任何想要補充能量或恢復元氣的人群 ◆ 有益於:
|
 20歲及以上人群的總體糖尿病患病率,以年齡段劃分——數據來自美國,2002年
來源於:基於1999—2001年國際健康問卷調查、1999—2000年國際健康與營養測試調查評估的結果,所制定的2002年規劃。 |
EUF 生態超能濾液LPPSIM
肝臟胰腺胎盤胃腸粘膜
| 器官 | 肝臟 | 胰腺 | 胎盤 | 胃 | 腸 | 粘膜 |
| 意義及作用 |
◆ 肝臟負責向血液中釋放或抑制葡萄糖。 ◆ 還發揮著其他很多重要的作用,例如解毒、及消化物質的分泌。 |
◆胰腺在必要時分泌及儲存胰島素。 |
◆ 胎盤是所有細胞及生命之源,含有極其充沛且適應力極強的細胞,富含養分及營養。 ◆ 胎盤在懷孕過程中主要起著新陳代謝的作用,並控制胎兒從母體獲取的荷爾蒙及其他能量。 |
◆ 在胃消化酶的作用下,食物被分解,並最終被小腸吸收。 ◆ 胃將食物向下轉移至小腸,進行進一步的消化。 |
◆ 腸部系統對於能量的管理發揮著很重要的作用。腸分泌的消化荷爾蒙對於葡萄糖及其他糖分的管理來說是不可缺少的因素。 ◆同時腸還能感知食物的攝入,並向肝臟發送停止分泌葡萄糖的信號。 |
◆ 粘膜分布於人體的洞孔部位,包括大部分呼吸系統,整個腸胃系統,以及口腔、耳朵和性器官。 ◆ 粘膜的健康尤為重要。因為粘液能夠粘住病原體細菌,防止疾病及細菌的進一步入侵。 |
|
糖尿病的危害 或 受其影響而衰弱且效率低下的器官 |
◆ 很多有糖尿病癥狀的人,即使體內血液裏的糖分水平已經很高,肝臟仍舊不停的分泌著新的葡萄糖。 ◆ 對胰島素的排斥,肥胖或高血壓,易導致脂肪肝。 |
◆ 一型糖尿病的情況下,免疫系統會影響胰腺,導致胰腺停止分泌胰島素。 ◆ 胰腺的衰退意味著人體已經無法獲取足夠的胰島素,來對糖分進行分解和消化。 |
◆ 胎盤的損傷可能是造成糖尿病患者腹中胎兒的先天性並發癥的部分原因。 ◆ 在所有的懷孕中,妊娠性糖尿病的發生率約為4%。這些病例中,20%至50%的人在5到10年裏有可能發展成為二型糖尿病。 |
◆ 高血糖會損傷神經,並導致胃部清空消化物所用的時間過長。糖尿病是造成腸胃麻痹的最常見原因。 ◆ 消化延遲致使血液葡萄糖的控制更加困難。無法預測消化情況,且人體的血液葡萄糖水平變得極不穩定 |
◆ 腸分布著許多與提升血液葡萄糖直接有關的神經。至於糖尿病患者以及有糖尿病癥狀的人,腸的衰弱會引起諸多問題。 |
◆ 有糖尿病癥狀的人,無論男女,都可能有外生殖器的瘙癢,且易受酵母菌感染(例如念珠菌等)。由於長期的高血糖導致神經損傷,引起男性陽痿等。 ◆ 许多患者抱怨口干舌燥 |
| EUF的功效!! | ★ EUF幫助恢復體力,改善肝功能,因此有助於調節葡萄糖以及凈化人體! | ★ EUF通過重新活化胰腺細胞,有助於人體內的胰島素恢復到最自然且健康的常規水平。 | ★ 對於懷孕的女性,胎盤萃取液能夠不僅僅能夠起到保護的作用,而且也可以幫助身體內細胞的再生和恢復系統的多元性。 | ★ 通過LPPSIM,胃功能得到超能濾液的特殊強化,幫助對於食物消化起著重要作用的胃細胞擺脫衰弱或病態,從而恢復正常。 | ★ 有了健康的腸,人體才能夠和身體各部分得到更好的協調,從而改善血液質量。 | ★ EUF幫助全身粘膜細胞恢復活力,強健免疫系統,以及人體的水分平衡。 |
EUF的成功體驗:一封來自客戶的感謝信
非 常感謝!我名叫Chow,70歲。我曾經患了多年嚴重的糖尿病。事實上去年8月,我病倒且入了院。在獲準出院後,我整天全身無力,幾乎每天下午都只能躺著 休息。醫生要求我每天做檢查,並且接受胃部的胰島素註射。那段時間就像是一種考驗,讓人灰心喪氣。後來從我兒子那裏得知了關於EUF產品的事。那時我想, 即使只是一個微不足道的經驗,如果EUF對改善生活質量有一點兒幫助的話,我也想要嘗試一下。僅使用了20瓶的療程,主治醫生對它的療效甚感驚訝。現在我 已經不必每天接受胰島素註射了!而且,我現在每天體力充沛,也不打瞌睡了!和妻子一起度過的時間也多了,我又重新體會到了生活的樂趣!真的非常感謝 !
EUF (生物細胞研究機構)
(幹細胞移植領域的領導者)
與
Dom AVMM AG實驗室的協作
(瑞士的細胞療法專家MFIII的研制者)
全新EUF生態超能濾液
EUF 生態超能濾液是從幹細胞中萃取出來的精華。有助於效率低下的或有缺陷的器官組織恢復活力,受擾的調節系統恢復常規,以及受疾病和衰老影響的人體功能 得到改善。它為生態構建基礎提供分子,從最大限度上促進人體的新陳代謝。生態超能濾液最主要幫助代謝,其次有助於分子的修復及更新換代。
歷史:EUF的發展歷程

40年前,對一位患者的治療方法的挑戰,揭開了生態超級濾液關於胎兒及幼體器官的研究的帷幕。一個8歲的女孩因暖爐爆炸而遭受了嚴重的燒傷,在她的經部以及右側臉部留下了極厚的毀容性疤痕。
 為了消除這個半英寸厚的疤痕,當時特別從胚胎皮膚中提取了細胞用於治療。這種療法非常成功,並且得到了進一步的研究和發展。
為了消除這個半英寸厚的疤痕,當時特別從胚胎皮膚中提取了細胞用於治療。這種療法非常成功,並且得到了進一步的研究和發展。
此項治療獲得成功以後,從皮膚中提取的細胞被廣泛應用於其他嚴重燒傷的且無其他治療方法的患者。在瑞士和德國的研究領域,通過對於各種超能濾液的療法範圍更廣泛的試驗,發現了諸多其他益處。
在 證明胚胎生態超能濾液能夠滲入完好的皮膚這一事實之後,它對於上皮組織的功效於1981年至1983年通過F Leyh的具有歷史意義的研究得到了證實。如果超能濾液能夠滲入皮膚,那麽很可能也同樣能夠透過粘膜到達所有體內器官及組織,也許比皮膚還容易滲透。觀察 發現了這一戲劇性的療效之後,生態超能濾液的管理部門提出了一種口頭方案。準備著手於研究生態超能濾液與肝臟、胰腺、胎盤、胃、腸、及粘膜的結合,來用於 改善受損的胃腸系統,以及用於治療諸如糖尿病一類的新陳代謝疾病。
這一突破性的研究結果開創了超能濾液與器官及組織的多種結合設想,為生物性地改善失調的器官系統以及器官的特定分子創造了條件。(應要求還有其他EUF適用的特定器官)
幹細胞移植技術:概述
幹細胞移植技術基於幾種科學原理,它們對於解釋生態超能濾液的治療方法的目的具有重要意義。 幹細胞移植技術是一種僅用於極少數病例的療法,它具有侵略性,復雜且昂貴(幹細胞移植的價格上限為20,000美元)。然而,EUF生態超能濾液運用同樣 的原理和技術,使得幹細胞技術不論從治療方面,還是從價格方面來說,適用於所有人。
1.無論屬於什麽特定的種類,同一種器官或組織的主要細胞幾乎都是相同的。
這表明了與不同種類動物的相同器官相符的細胞從生物學上來講其實是一樣的。例如肝臟器官,脊椎類動物肝臟的主要細胞幾乎是一樣的。我們因此能對人體和動物體內的約200種細胞,做出類似聲明。科學家稱這個為 “器官特異性原理”。
動物和人類同種器官的細胞幾乎不存在什麽排異性(抗體的產生)區別。這就更加證明了"器官特異性"的原理。
2.自然界所有生物體系皆由同一類型分子所組成。
各種生物的極大多數蛋白質的整體氨基酸順序排列都是相同的。也就是說,它們屬於同一性質,而且基本上功能也相同。科學家稱這個為“同源原理”。
這也同樣適用於所有其他類型的分子。尤其是那些輕質量的分子,這些分子在所有個體細胞以及諸多組織和器官的細胞裏起著控制器的作用。
為了更有效的利用幹細胞移植技術療法的益處,科學家們通過動物胚胎試驗,研制出了多種器官和組織的生態濾液,口服用於輕度癥狀以及類似癥狀的治療。
運用幹細胞技術,EUF生態超能濾液在分子水平上為生物構建基礎恢復活力及更新換代提供了支持。
EUF 生態超能濾液
|
EUF生態超能濾液(EUF)是專為器官準備的,由含動物胚胎細胞的分子組成,該分子的直徑以納米來計算。 適 用於多種器官及組織的生態超能濾液由EUF生產,有助於平衡及補充多種人體生物系統。例如中樞神經系統,免疫系統,腸胃系統等。EUF生態超能濾液為各 個器官、組織及不適提供諸多產品,包括從胎盤中提取的成分。生態超能濾液療法的適用範圍包括慢性疾病造成的功能性衰弱,慢性衰退性疾病,以及由於衰老等引 起的衰退及效率低下 |
 此成品不含細胞,但極具生物活性,經無菌處理,是安全的液體提取物。 |
反應及效用
|
因為生態超能濾液體積小,且其有機組成分子質量輕,易透過完好的粘膜而被吸收(通過口服)。 療效取決於生態超能濾液的內含物質,從分子水平為細胞的“生物構建”提供幫助。主要促進代謝,同時有助於分子的修復及更新換代,為此同一性的(器官類別)分子也必不可少。
|
決定性因素在於,生態超能濾液符合器官特質,及系統類別,它由分子結構組成,促進針對性治愈以及恢復活力。 決定性因素在於,生態超能濾液符合器官特質,及系統類別,它由分子結構組成,促進針對性治愈以及恢復活力。 |
過程:
吸收>>> 輸送 >>> 合成 >>> 生效
從開始服用,到發揮明顯的效用,人體對於生態超能濾液的反應通常需要經過3至4周
EUF生態超能濾液(EUF)是根據器官特質或系統特性來設計的,由幹細胞分子組成,因此對於人體諸多不適均有療效。

EUF 生態超能濾液是從含有動物胚胎組織及器官分子的幹細胞內提取的,它質量極輕(不超過10,000 道爾頓)。更不可置信的是,它的直徑僅為目前已知最小病毒的直徑的大約1/9。(通過顯微鏡觀察最小的病毒的直徑尚有27納米)。在生產過程中,通過多次 重復的顯微網過濾,細胞及其他高質量的分子被從低質量的分子分離開來。因此最終產品不含任何細胞及蛋白質,但是極具生物活性,且含有分子元素,其名義上的 質量為10,000 Da (道爾頓)。
生態超能濾液不含化學添加物。尚未產生任何不良反應。
EUF生態超能濾液從含有胚胎 器官或組織幹細胞中提取,該細胞來源於相近種群的兔子。*應美國FDA以及世界衛生組織(WHO)的要求,在本過程中禁止殺死兔子。* 根據一項自從1973年來維持了25年的規定,此規定已受到認證,而且是按照WHO、FDA、及AAALAC(提倡愛護試驗動物的評估組織)的方針來制定 的。
用法和儲存方法
生態超能濾液一個療程的用量分為20,40,及60瓶三種。請於三餐之間服用。
服用瓶內液體時請註意不要立即吞咽,為了有效吸收,請將液體含在口中等待約10到30秒後再吞咽。
請將EUF生態超能濾液保存於冰箱內,最適宜溫度為+2°C 至 +10°C之間(非冷凍),最長保質期為6年。存放時請註意避開日光直射處。
糖尿病 (糖尿病) 與EUF 生態超能濾液 LPPSIM
|
自1998年以來,證實EUF生態超能濾液LPPSIM 肝臟,胰腺,胎盤,胃,腸,粘膜)對於抵抗所有類型的糖尿病均有效,支持人體恢復常規及正常分泌胰島素。 EUF嚴格按照GMP(優良生產守則)的標準,擁有超過25年的經驗和研究,以及幹細胞移植技術應用於糖尿病患者治療的臨床經驗。 由EUF利用幹細胞移植技術研制的超能濾液意味著不再有免疫系統受損的隱患。 |
 联合国的糖尿病标志 |

這對於糖尿病的治療尤為重要。糖尿病的免疫系統受損這一特殊原因,會引起胰島亞細胞對於新陳代謝的需求增加,以至於胰腺本身有限的分泌胰島素的能力被耗盡。
諾貝爾物理獎獲得者Alexis Carrel認為,胰島素並不能夠治愈糖尿病。這句話仍然沿用至今,直至美國著名的DCCT(糖尿病控制及其並發癥研究)之後。胰島素雖然能抑制糖尿病的發展,但是始終無法消除令人生畏的糖尿病並發癥。
所有糖尿病並發癥的原因仍然不為人知,但是可能是由於缺乏其他物質,也許是一種未知的由胰島細胞,或者由內分泌調節系統的多種細胞分泌的荷爾蒙、碳水化合物、或脂質代謝物。
通過服用EUF生態超能濾液 LPPSIM 有助於人體的整體解毒及由於胰島素分泌失調的作用導致的免疫系統衰退情況的改善,以及高血糖的緩解和恢復活力!
EUF 生態超能濾液LPPSIM通過從胰腺和胎盤提取的幹細胞增強胰島細胞及免疫系統的活力,同時肝臟,胃,腸及粘膜的幹細胞提取物也幫助增強肝臟和消化系統功 能。消化系統易受血液中高葡萄糖含量的影響。胰腺的器官移植已經被實行了幾年,但是由於胰腺移植並發癥的高發率,即使是現在的醫療技術,每年也只能有大約 1,300名患者接受移植。因此胰腺移植術通常與腎臟移植一起施行,這使原本就已經高額的手術費用變得更加昂貴。
EUF LPPISM並不是胰島素的替代物,卻能夠通過向一些與糖尿病情況有直接聯系的器官提供必需的分子元素,顯著幫助增強人體的自然調節力。它有助於降低註射胰島素的必要及頻率,而且在一些特殊的病例中,有些患者表示他們已經不再需要註射任何胰島素註射。
EUF 生態超能濾液的物質構成如此完美而纖巧,因此它能夠直接被口腔內的細胞膜吸收,且只需口服,無需註射。
* 關於應用於糖尿病及其並發癥治療的幹細胞移植技術的詳情,可以查閱E. Michael Molnar所著的書——由華盛頓特區醫療及工程出版社出版發行的M.D. "幹細胞移植技術,一本關於外部幹細胞移植技術的書"。這是有關這項研究的首本面向醫療專家及學生出版的書。